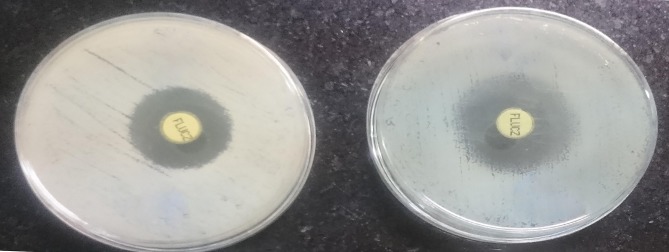

Abstract
Purpose
Antifungal resistance and virulence properties of Candida albicans (C. albicans) are growing health problems worldwide. The present study aims to investigate the effect of Zinc Oxide (ZnO) nanoparticles and Nystatin on SAP1-3 genes expression in C. albicans isolates of females with Vulvovaginal Candidiasis (VVC) isolated from Sayad Shirazi Obstetrics and Gynecology Hospital in Northeastern Iran during 2017–2018.
Patients and Methods
In this descriptive-analytic study, vaginal samples were collected from 280 VVC women. 196 (70%) of C. albicans isolates were identified by phenotypic and ITS genotypic methods. Susceptibility to Fluconazole C. albicans isolates was determined by the disk diffusion method. Detection of ERG11 gene was done by RT-PCR technique.
Results
It was revealed that PCR amplified the ERG11 gene in all of the Fluconazole-resistant isolates. Real-time PCR was used to survey the effects of 3±1.7µg/mL concentrations of ZnO nanoparticles and Nystatin on expression of SAP1-3 genes before and after treatment. 186 (95%) susceptible C. albicans and 10 (5%) Fluconazole-resistant C. albicans isolates from VVC were exposed to sub-minimum inhibitory concentrations (Sub-MIC) of ZnO-np (range=0.02–12 μg/mL). Sub-MIC concentration was used for each strain, which reduced the expression of SAP1-3 genes to 1.8 MIC in the vaginal swabs. The observed reduction in gene expression was significant for both ZnO nanoparticles and Nystatin (P=0.01 and P=0.07, respectively).
Conclusion
ZnO as antifungal agent can well reduce the growth and gene expression of SAP1-3 in the pathogenesis of VVC.
Keywords: ZnO, gene expression, pathogenesis, vulvovaginal candidiasis
Introduction
Vulvovaginal candidiasis (VVC) is one of the most common gynecologic infections in women that are seen daily in clinics.1 In 85–95% of patients, vaginal fungal infections are caused by Candida albicans (C. albicans), and in the rest, Candida glabrata and Candida tropicalis are the main causes of the disease.2
Increasing the resistance of C. albicans to antifungal agents, mainly to azoles, is a serious health problem and prevents VVC treatment. Resistance of candida species against antifungal agents can infect approximately 5% of women at least four times a year.3–5 The causes of the increasing incidence of VVC could be low-dosage azole maintenance regimens and the use of antifungal agents such as Fluconazole without a prescription.6–8
Predisposing factors for VVC include reproductive age, use of contraceptive steroid medications and bacterial antibiotics, and being diabetic, pregnant, or immunocompromised. Increased Fluconazole-resistance is nowadays one of the most important problems in the long-term treatment of recurrent VVC. Resistance to Fluconazole may occur through various mechanisms including alpha-demethylase in sterol biosynthesis that enhances the expression of ERG11 gene.
Overexpression of ER11 gene results in the production of a large amount of Lanosterol 14α-demethylase; this helps to continuous synthesis of ergosterol and maintaining the cell wall integrity that can cause the candida be resistant to Fluconazole.6–9 This type of resistance has been associated with widespread and continuous usage of Fluconazole as prophylaxis.6 Also, mutations in the ERG11 gene exist and contribute to resistance in about 65% of Fluconazole-resistant candida species.6,10 Among the Fluconazole-resistant isolates, mutations in the ERG11 gene among the candida species are responsible for significant differences in their susceptibility to Fluconazole.11
Secreted Aspartyl Proteinases (SAP) are considered as a potential factor that may affect the virulence of this yeast. Extracellular proteolytic activity of candida species is caused by SAP. As the best member of the hydrolytic enzyme group, SAP play an important role in adhesion, colonization, penetration and tissue attack by destroying cell membranes and host surface molecules.12 SAP are coded by 10 families of the SAP genes; all are effective in C. albicans pathogenesis.13,14 According to previous studies, SAP1-3 genes are involved in mucosal infections. SAP1 and SAP3 play important roles in the adhesion of C. albicans. SAP2 plays an important role in C. albicans colonization at vaginal mucosal surface and development of C. albicans pathogenesis.15 Therefore, inhibition of SAP has a protective effect on the host.16
Nystatin is one of the drug combinations used to treat recurrent VVC. It belongs to the polyenes family, which changes the membrane permeability by binding to the sterols in the fungus cell membrane and causes the essential contents of the intracellular fungi to be removed. In this study, Nystatin was used for treatment of VVC infections. Then, Nanomaterials were used to inhibit the growth of VVC isolates.
The main principle of nanotechnology is the application of new compounds with nanoscale structures. Booster nanocomposites of ZnO have been studied in the last decade, remarkably. The reasons for using ZnO are its high energy bandgap, chemical and thermal stability, high oxidation energy (60mev), and good antimicrobial properties.
ZnO has been used for long years such that the Romans called it “cadmium” and used it to produce rice alloys. Metallic ions like silver and copper have traditionally been used to treat diseases.17 ZnO improves durability and resistance to mildew; it has also been used in the pharmaceutical and cosmetic industries in powder and ointment forms.18
ZnO increases the permeability of the cell wall and cytoplasmic membrane through binding to lipids and proteins and the destruction of protein’s 3-D structure.17
We conducted Fluconazole susceptibility testing on the clinical C. albicans isolates obtained from some young VVC women. The resistant strains and susceptible dose-dependent species were subjected to polymerase chain reaction using primers that identify ERG11 gene expression. We investigated the secretion of SAP and their activity in VVC strains. There is a clear link between the ability to produce SAP and the development of disease in Fluconazole-resistant strains.19,20 In addition, we investigated the antifungal effect of ZnO nanoparticles and Nystatin on inhibiting the growth of VVC C. albicans isolates. Subsequently, the analysis of the expression of SAP1-3 genes in C. albicans isolates was performed using real-time PCR. Additionally, changes in the expression of SAP1-3 genes were determined by Real-time PCR after the addition of sub-inhibitory concentrations of ZnO-np and Nystatin onto VVC C. albicans isolates.
Materials and Methods
Sampling, Culture, and Identification of Yeasts
This descriptive cross-sectional study was carried from August 2017 to July 2018 in Sayad Shirazi teaching hospital of Golestan University of Medical Sciences. Approval for the study was granted by the Ethics Committee of Golestan University of Medical Sciences.
Inclusion criteria were vaginal swabs from the VVC women willing to participate in the study. The drug susceptibility test of Nystatin and ZnO nanoparticles in VVC C. albicans isolates was done by previous informed consent of the participants.
All procedures performed in studies involving human participants were in accordance with the rules on patient sampling and fully complied with the Ethics Committee (Code no.IR.Gums.rec.1397.008) and with the 1964 Helsinki Declaration and its later amendments or comparable ethical standards. Written informed consent was obtained from all participants, and the questionnaire was sent to the journal as an Additional File.
A semi-structured questionnaire was administered after explaining the details of the study and obtaining their consent. The vaginal samples were obtained from 280 patients (aged 18–46 years) suffering from burning, itching, malodorous and cheesy vaginal secretions, with a confirmed diagnosis by Dacron swabs. The vaginal swab specimens were collected by the attending physician following standard procedures.3
The yeasts were first identified according to their morphological characteristics using several phenotypic techniques such as production of germ tube in human serum, culture on CHROMagar Candida (Chromagar, France), and Cornmeal agar (Sharlo, USA), containing Tween 80.10 After identification of primary morphology, DNA extraction was performed using the Phenol-chloroform-isoamyl alcohol method. DNA was amplified using the ITS1 (5ʹ- TCC GTA GGT GAA CCT GCG G-3ʹ) and ITS4 (5ʹ- TCC TCC GCT TAT TGA TAT GC-3ʹ) primers, which were used for PCR amplification of the ITS1-5.8S-ITS2 rDNA region. Both VVC isolates and standard strain of C. albicans produced bands with an approximate length of 535 bp (Figure 1). Digestion of the ITS region of C. albicans using HpaII enzyme produced two bands of 297 and 338 bp.21
Figure 1.
Identification of VVC C. albicans isolates.
Susceptibility Testing of Isolates to Fluconazole by Disk
The standard disk diffusion assay (Clinical and Laboratory Institute (CLSI) M44-A2) was used. In summary, 1×106 CFU/mL yeasts were prepared for each suspension in a Buffered Phosphate Solution (PBS) and distributed on Mull-Hinton (MH) agar with 2% glucose and 0.5μg/mL Methylene blue. Fluconazole (Rosco, France) was used as a positive control. Fluconazole disks (25μg) were placed on the agar, and PBS (as negative control) was added to the blank disk. Then the M-H agar plates were incubated for 24 hrs at 37°C and the diameter of the non-growth zone was measured.22 C. albicans isolates were reported as susceptible S (zone diameter ≥19 mm), susceptible dose-dependent SDD (15 to 18 mm), and resistant R (≤14 mm). 10 (5%) isolates showed resistance to Fluconazole while 18 (9.13%) were susceptible to dose-dependent and 168 (85.71%) were susceptible.
Reverse Transcription-PCR (RT-PCR) Analysis of the ERG11 Gene
RNA was extracted from the C. albicans isolates using TRIzol™ reagent (Catalog#15596026, Invitrogen, Thermo Fisher Scientific, Waltham, MA, USA) according to the manufacturer’s protocol. Before the synthesis of cDNA, all samples of RNA were treated with DNase1 (Thermo Fisher Scientific Co., EN0521, USA). Synthesis kit of cDNA (Fermentase Co., K1622, USA) was utilized for the synthesis of cDNA. Primer pair with the Accession Number: XM_711668.2, 5′- CTTGGTTTGGTTCTGCAGCTT −3′ (forward) and 5′- ACATTGGCAACCCCATGAGT −3′ (reverse) was designed to amplify an expected PCR product of 397 bp, which includes the complete ERG11 gene sequence. The PCR was performed in a Thermocycler (Eppendorf, Germany). The system was programmed to 2 min of denaturation at 92°C followed by 30 cycles, each consisting of 1 min of denaturation at 92°C, 1 min of annealing at 43°C, and 1 min of extension at 72°C. At the final cycle, an additional 10 min of incubation at 72°C was performed for a complete extension. For each PCR run, a negative control was also included containing the reaction buffer, dNTPs, Taq polymerase without the target DNA. Reference strain C. albicans ATCC10231 was included in each run. The ERG11 gene was detected by electrophoresis on a 2% agarose gel performed at 70 V for 2.5 hrs. The gel was stained with ethidium bromide (0.5 μg/mL) and photographed under UV light with a Photo documentation system (GenoSens 1500). A DNA ladder of 100 bp (Promega, USA) was used as molecular weight marker.23
Antifungal Drug Susceptibility Testing of ZnO and Nystatin on VVC C. albicans Isolates
ZnO was synthesized by the sole gel method24 was prepared in 1mL distilled water, and Nystatin (1477003, Sigma Aldrich) was prepared in 1 mL DMSO 10%. The inhibitory effects of ZnO and Nystatin were tested on the surface of 96-well microplates using the CLSI M27-A3 method. Absorption was measured after incubation for 48 hrs at 30°C. MIC (Minimum Inhibitory Concentration) was determined by comparing it with the control group without the drug. For ZnO and Nystatin, MIC was determined by a significant reduction in growth after 48 hrs of incubation. MIC was considered to be the lowest concentration in which growth was reduced. To ensure non-growth, a negative control was considered for each isolate.23
Effect of ZnO Nanoparticles and Nystatin on the Growth of VVC C. albicans Isolates Using the MTT
The effect of ZnO nanoparticles and Nystatin on the growth of C. albicans isolates was assessed according to the CLSI-M27-A3 guidelines.19 Briefly, C. albicans isolates from the overnight-grown cultures in YPD broth were harvested by centrifugation and adjusted to a final concentration of 1 × 106 cell/mL in RPMI-1640 medium. 100 µL of the cell suspension was added to each well of the 96-well microplates (Thermo Scientific Nunc Microwell). ZnO-np dissolved in water was added to the wells to achieve a two-fold series of concentrations of ZnO, ranging from 0.02 µg/mL to 256 µg/mL. The wells containing the same volume of water were set as negative controls, while the wells treated with 8 µg/mL Nystatin were served as positive controls. The wells containing only medium were served as blank controls. After incubation at 37°C for 24 hrs, the inhibitory effect of ZnO was assessed by visual inspection. Then, 10 µL of sterile MTT solution (5mg/mL in PBS) was added to each well of the microplates, followed by another incubation at 37°C in dark for 4 hrs. The supernatant in each well was discarded, and then 100 mL of DMSO water-soluble supernatant was added to each well.
An Eliza Reader was used to capture the optical absorption of the 96-well microplates (Nank, Germany) (OD) at 570 nm. The vitality of the fungal cells in each well was calculated as a percentage of surviving cells =(1-X/C)×100
X:OD570 treatment, C: OD570 control.
All assays were performed in triplicate.25
Analysis of SAP1-3 Genes Expression Level in VVC C. albicans Isolates
Analysis of the SAP1-3 genes expression in VVC C. albicans isolates was performed in the presence and absence of sub-MIC concentrations of ZnO-np (2–18.1μg/mL) and Nystatin (0.031–128μg/mL). RNA was extracted from the C. albicans strains using TRIzol™ reagent (Catalog #15596026, Invitrogen, Thermo Fisher Scientific, Waltham, MA) according to the manufacturer’s protocol. Before cDNA synthesis, all samples of RNA were treated with DNase1 (Thermo Fisher Scientific Co., EN0521). Synthesis kit of cDNA (Fermentase Co., K1622, USA) was utilized for the synthesis of cDNA.
Real-Time PCR
The Primers designed by the PRIMER3 web-based software (http://frodo.wi.mit.edu/primer3) were used for real-time PCR analysis.
The primers were checked for specificity through the BLAST search available on the NCBI website (http://blast.ncbi.nlm.nih.gov/Blast.cgi). A primer set for the hemochromatosis gene was designed to be used as an internal control (Table 1). Amplification and detection of SAP1-3 genes expression in the presence of sub-MIC concentrations of ZnO and Nystatin was performed using the Real-time PCR with the Rotor-Gene SYBR Green PCR kit (Amplicon) with specific primers listed in Table 1 for SAP1 [GeneBank: XM_712960.1], SAP2 [GeneBank: XM_705969.1], SAP3 [GeneBank: XM_718117.1], and ACT1 [GeneBank: XM_717232.1].13 The final volume of each reaction was 25 μL, consisting of 12.5 μL of the SYBR Green Master Mix, 1 μL of forward primer (1 μM), 1 μL of reverse primer (1 μM), 2 μL of cDNA (~20 ng), and 8.5 μL of RNase-free water.
Table 1.
The Specific Primer Sequences and PCR Product Length
| Sequence (5´–3´) | Primer | Product Size (bp) | Accession Number |
|---|---|---|---|
| GTTGGTTTTGGTGGTGCTTC GCAGCATTGGGAGAGTTGAG | SAP1F SAP1R |
161 | XM-712960.1 |
| TGTGGATTCAGGTACCACCA GCAAATTCGGAAGCTGGA | SAP2F SAP2R |
192 | XM-705969.1 |
| TGGTCAAGGACAAGATCCAA CCAATCCCTAAAATCCCTTG | SAP3F SAP3R |
231 | XM-718117.1 |
| CCAGCTTTCTACGTTTCC CTGTAACCACGTTCAGAC | ATC1F ATC1R |
209 | XM-717232.1 |
Thermal cycling was performed in the ABI system 7300 (Applied Biosystems, Foster City, CA) scheduled to 95°C for 10 min (enzyme activation), 40 cycles of 95°C for 10 second (denaturing), 58°C for 15 second (annealing), and 72°C for 30 second (extension). Negative (water) and positive (C. albicans ATCC10231) controls were included in each run. The SAP1-3 genes expression was normalized to the ACT1 housekeeping genes, and evaluated using the 2–ΔΔCt method.
Data were presented as transcriptional mRNA (preferred units) relative to ACT1 or equal difference in expression relative to the preculture cell. Each experiment was performed in three replications, and the reactions (25 mL) were also performed in three replications.
Statistical Analysis
To analyze the obtained data, the significance level was considered at P<0.05. The statistical software of Rest (ver. 2009) was used to test the ratio of target and reference molecules. For this purpose, the expression of the target gene was normalized to the gene expression of ACT1 as a reference gene. Data were entered into the SPSS software (ver. 16) and the results were analyzed by the one-way ANOVA. P ≤ 0.05 was regarded as statistically significant.
Results
Identification of VVC C. albicans Isolates
Overall, 196 out of the 280 direct smeared samples were culture positive with five different yeast strains, 53.6% of which were C. albicans. All of these samples were detected by phenotypic and genotypic methods (Figure 1).
Susceptibility Testing of Fluconazole Against VVC C. albicans Isolates by Disk
C. albicans strains were reported as susceptible S (zone diameter ≥19 mm), susceptible dose-dependent SDD (15 to 18 mm) and resistant R (≤14 mm). In this study, a disk diffusion test was used to determine the susceptibility of the samples to Fluconazole. Clinical specimens were divided into three groups based on the zone of inhibition of growth: less than 14 mm, 10 resistant isolates; 14–21 mm, 18 intermediate isolates; and more than 21 mm, 168 sensitive isolates. The ERG11 gene was tested in the Fluconazole-susceptible, intermediate and Fluconazole-resistant strains. 10 Fluconazole-resistant isolates had ERG11 gene expression; 18 intermediate and 168 Fluconazole-sensitive isolates had no ERG11 gene expression. Therefore, 196 isolates were divided into two groups of 10 Fluconazole-resistant and 186 Fluconazole-susceptible isolates based on their level of ERG11 gene expression. Zones of inhibition showing the interpretive categories in accordance with the disk diffusion technique are presented in Figure 2A and B. ERG11 gene was amplified and detected in five resistant C. albicans isolates (Figure 3).
Figure 2.
Susceptibility pattern of C. albicans isolates to Fluconazole (25 µg) showing different sizes of inhibition zone: (A) 14 mm (R), and (B) 22mm (S).
Figure 3.
Agarose gel electrophoresis of the amplicon lane M: DNA marker, lane 1, positive control; (+) lane 6, negative control;(–) and lanes 2–4 visible amplification of ERG11 gene with a band size of 397 bp for Fluconazole-resistant C. albicans isolates.
Antifungal Drug Susceptibility Testing of ZnO and Nystatin Against VVC C. albicans Isolates
To investigate the antifungal effects of ZnO nanoparticles and Nystatin, C. albicans isolates were exposed to various concentrations of these drugs. It was observed that all isolates were sensible to ZnO and Nystatin, and had inhibitory activity in low concentrations (Table 2). The lowest MIC value of ZnO nanoparticles and Nystatin was 2 and 0.6µg/mL, respectively. The MIC measurement revealed that both ZnO nanoparticles and Nystatin might be good inhibitors of candida isolates (Table 2).
Table 2.
In vitro Susceptibility Testing of VVC C. albicans Isolates Against ZnO Nanoparticles and Nystatin
| Strains | Antifungal Agents | MIC Range (µg/mL) | MIC 50% | MIC 90% |
|---|---|---|---|---|
| C. albicans (n=10) | ZnO nanoparticles | 0.02–269 | 5 | 11.3 |
| Nystatin | 0.6–32 | 3 | 8 |
Abbreviations: MIC50, Minimum Inhibitory Concentration 50%; MIC90, Minimum Inhibitory Concentration 90%.
Determining Is the Effect of the Sub-MIC Concentration of ZnO-np and Nystatin on VVC C. albicans Isolates by MTT Test
We performed antifungal tests according to the CLSI-M27-A3 guideline. As shown in Figure 4, the sub-MIC concentration of ZnO nanoparticles and Nystatin against VVC C. albicans isolates was 11.1 and 4 µg/mL, respectively, indicating that more than 50% of the C. albicans isolates were viable at the sub-MIC concentrations of ZnO nanoparticles and Nystatin (11.1 and 4 µg/mL, respectively).
Figure 4.
The antifungal activity of ZnO nanoparticles and Nystatin on VVC C. albicans isolates: (A, B) MIC values of ZnO nanoparticles and Nystatin against C. albicans were determined by microdilution method. The isolates were incubated with various concentrations of ZnO nanoparticles and Nystatin for 24 hrs before conducting the MTT assay.
SAP1-3 Genes Expression in VVC C. albicans Isolates
Sensitive C. albicans strains showed lower expression of the target genes, while Fluconazole-resistant strains showed a significant increase in the expression of SAP1-3 genes. SAP1-3 genes expressions level was higher in 10 isolates (Fluconazole-resistant) comparing to that of 18 SDD and 168 sensitive isolates. The mean of target gene expression level SAP1-3 in the resistant isolates was significantly higher than in the sensitive strains (P <0.001) (Table 3).
Table 3.
SAP1-3 Genes Expression Level in Vulvovaginal C. albicans Isolates
| Evaluated Genes | Strain Number | SAP1-Gene Expression (%) | SAP2-Gene Expression (%) | SAP3-Gene Expression (%) |
|---|---|---|---|---|
| Number of Fluconazole-resistant strains | 10 | 10 (100%) | 9 (90%) | 6 (60%) |
| Number of SDD | 18 | 18 (100%) | 15 (83%) | 12 (67%) |
| Number of susceptible strains | 168 | 148 (88%) | 148 (88%) | 118 (70%) |
Downregulation of SAP1-3 Genes Expression in VVC C. albicans Isolates Affected by Different Sub-MIC Concentrations of ZnO Nanoparticles in Comparison to Nystatin
In this model, the target gene expression was normalized by ACT1 expression, which is a reference gene. The normalized value was then applied to compare differential gene expression in different samples.
The candida strains were treated with different sub-MIC concentrations of ZnO nanoparticles and Nystatin. The gene expression of SAP1 was decreased about 2.44 times after treatment with ZnO nanoparticles comparing to the control group (untreated) (P<0.02).
It was also decreased around 4.16 times after treatment with Nystatin (P<0.01) (Figure 5). The gene expression of SAP2 in the strains indicated a decrease of 3.12 and 5.55 times after treatment with Nystatin and ZnO nanoparticles, respectively (P<0.03) (Figure 5). Also, the gene expression of SAP3 was remarkably decreased about 2.6 and 4.8 times after treatment with ZnO nanoparticles and Nystatin, respectively (P<0.05) (Figure 5).
Figure 5.
Comparison of the expression of SAP1-3 of VVC C. albicans isolates with 3±1.7µg/mL concentrations of ZnO-nanoparticles and Nystatin compared to the calibrated gene in the control group (Value of the nonadjacent samples was zero). The ACT1 gene was used as an internal control (P<0.05). The numbers were obtained as mean ± standard deviation (SD) after three replicates.
Discussion
Among the isolates studied, nearly 53.6% (196/280) were from VVC patients and 15% (43/280) were from RVVC patients. In some reports from Iran, the incidence of VVC was 5-10%,12 33.3%13 and 47.3%.5 We found that the frequency of VVC in our study is higher than the rates found in Nigerian [14.0%], Indian [20.47%], and Turkish [16%] studies.1,23,25 In the present study, the species distribution of C. albicans isolates was similar to the study of Shi et al and Yano et al.11,12 There are limited data regarding the antifungal susceptibility of yeast species causing VVC. Our study indicated that the ratio of resistance to Fluconazole C. albicans isolates from VVC was 5% (10/196), which is significantly higher than the rate in Southern China,11 indicating differences in the genotype of the circulating isolates or in the frequency of the use of Fluconazole in different regions of China.
These changes can be due to the social and economic characteristics of sample individuals, as well as the knowledge of patients about personal health and self-treatment.
The Fluconazole resistance rate in the RVVC group was significantly higher than in the VVC group; this indicates that more increased fluconazole use of Fluconazole can generate Fluconazole resistance in candida species due to overexpression of ERG11 gene.6
In this study, PCR amplified ERG11 gene expression in ten resistant isolates. Constant exposure of candida species to Fluconazole has frequently been associated with resistance. This study analyzed SAP1-3 genes expression in C. albicans isolates during vulvovaginal infection.
It was revealed that the average level of SAP in C. albicans was significantly more in the Fluconazole-resistant isolates than in the sensitive C. albicans strains (Figure 5). In addition, the SAP1-3 genes expression was increased in the Fluconazole-resistant C. albicans strains comparing to the sensitive C. albicans strains. This indicates a clear link between the expression of SAP1-3 genes exposure to antifungal agents and their drug resistance. The results of the present study imply that the importance of SAPs for pathogenicity during vulvovaginal infections. However, the expression levels of SAP1 and SAP3 were higher in the Fluconazole-resistant C. albicans isolates than in the sensitive C. albicans isolates. We also found that the expression level of SAP2 was significantly greater in the Fluconazole-resistant strains than in the sensitive C. albicans isolates. This indicates the importance of SAP2 in the development of pathogenesis C. albicans (P <0.05) (Figure 5). These results are in agreement with the results of Hosseini et al, who showed that the total surface area of SAP1-3 mRNA was higher in Fluconazole-resistant C. albicans isolates than in the sensitive strains.14
Hence, it seems necessary to find new compounds to treat drug resistance to antifungals. Nystatin is a polyene antifungal that is frequently used as a topical agent in the treatment of VVC.1 We previously reported22 the antifungal effects of ZnO nanoparticles on the growth inhibition of standard strains of urinary catheter C. albicans in comparison with Fluconazole drug.19 This is the first study to investigate the effect of ZnO on SAP1-3 genes expression in VVC C. albicans isolates. Previous investigations have identified the effects of ZnO-np and sodium dodecyl sulfate on the growth inhibition of standard strains of C. albicans in comparison with Fluconazole drug.25 The MIC results of ZnO nanoparticles on Fluconazole-resistant VVC C. albicans isolates showed that the nanoparticles have intensive antifungal property.
The results of drug susceptibility testing of C. albicans isolates in the presence of ZnO nanoparticles and Nystatin revealed that the highest sensitivity of isolates to ZnO was MIC90≥0.5μg/mL compared to the non-treatment control samples (Table 1). These results agree with the finding of Kanathila et al, who showed an antifungal effect of Magnesium Oxide, ZnO nanoparticles, Silicon Oxide and Copper Oxide nanoparticles against the growth of C. albicans.7,17,26 Also, Sardella et al reported that ZnO-np could inhibit the growth of Penicillium expansum by automated turbidometric analysis.7,22 Therefore, ZnO seems to be an active ingredient for the control, prevention, and treatment of Candidiasis. In several studies, Nystatin was used for treating VVC patients with Fluconazole-resistant C. albicans isolates.
A study conducted by Hosseini et al13 found that C. albicans resistant to azoles showed a higher SAP activity than the susceptible isolates. Similarly, in this study, Fluconazole-resistant strains were shown to increase the expression of SAP.17,27 We used sub-MIC (3±1.7µg/mL) concentrations of ZnO nanoparticles and Nystatin to inhibit the expression of SAP1-3 genes. The results revealed that both ZnO and Nystatin decreased the SAP1-3 genes expression in all isolates that is in accordance with the findings of Cho et al.10,28–30 This finding shows that ZnO nanoparticles 5±1.3µg/mL and Nystatin 3±1.3µg/mL significantly reduced the SAP1-3 genes expression in Fluconazole-resistant VVC C. albicans isolates (P<0.05) (Figure 5).
ZnO has high permeability to the cell wall and cytoplasmic membrane through binding to lipids and proteins and denaturing through the destruction of the 3-D structure of proteins.26 In total, the present research findings confirmed that low concentrations of ZnO nanoparticles and Nystatin reduced the expression of SAP1-3 genes in Fluconazole-resistant isolates.
Conclusion
This is the first work done in Sayad Shirazi Obstetrics and Gynecology Hospital in Northeastern Iran on the expression of different virulence markers and azole resistance genes in clinical isolates of C. albicans. We identified the importance of SAPs1-3 genes role in the pathogenesis of Fluconazole-resistant VVC isolates; hence, we decided to use ZnO-np and Nystatin to inhibit the activity of these genes. Therefore, for the first time, Nystatin and ZnO nanoparticles (that we synthesized ourselves) were used to inhibit the activity of Aspartyl Proteinase Secreted in Fluconazole-resistant C. albicans VVC isolates. ZnO has a high cell wall and cytoplasmic permeability to the membrane by binding to lipids and proteins, and by destroying the 3-D structure of proteins.17 The highest expression of SAP1-3 genes was observed in VVC Fluconazole-resistant C. albicans isolates with ERG11 gene.13
Each of these genes can enhance the resistance of the organism to antifungal drugs by different molecular mechanisms.31,32 These results indicate that ZnO-np can be more effective in inhibiting the growth and activity of fungi by different mechanisms compared to Nystatin as an antifungal agent. According to the current research results and numerous tests of nanoparticles, these ingredients appear to be suitable for eliminating the infection in combination with new pharmaceutical formulations along with antifungal chemical drugs conjugated with medications. Therefore, there is a need for further studies on natural target cells, such as human vaginal epithelial cells as well as in vivo studies on mouse models to clarify whether ZnO nanoparticles could be applicable as an alternative antifungal.
Acknowledgments
The current study was extracted from a research protocol approved by Golestan University of Medical Sciences, Gorgan, Iran. The study was approved by the university‘s Ethics Committee (Code no. IR. Gums. rec. 1397.008).
Ethics Statement
Inclusion criteria were vaginal swabs from women with vulvovaginal candidiasis who tended to participate in the study.
All procedures performed in studies involving human participants were in accordance with the rules on patient sampling and fully complied with the Ethics Committee of Gorgan University of Medical Sciences (Code no. IR.Gums.rec.1397.008) and with the 1964 Helsinki Declaration and its later amendments or comparable ethical standards. Written informed consent was obtained from all participants, and the questionnaire was sent to the journal as an additional file.
Data Sharing Statement
All data are presented in the manuscript or as additional files.
Author Contributions
HSS conceived the study, participated in its design and analysis of the results and revised the manuscript. JHR, ST, AA and MZ participated in the design and coordination of the study, contacted the drug regulatory authorities, analyzed the results and drafted the manuscript. All authors gave final approval of the version to be published, and agree to be accountable for all aspects of the work.
Disclosure
The authors declare that they have no conflicts of interest.
References
- 1.Ahmad A, Khan AU. Prevalence of Candida species and potential risk factors for vulvovaginal candidiasis in Aligarh, India. Eur J Obstet Gynecol Reprod Biol. 2009;144(1):68–71. doi: 10.1016/j.ejogrb.2008.12.020 [DOI] [PubMed] [Google Scholar]
- 2.Monroy-Perez E, Paniagua-Contreras G, Vaca-Paniagua F, Negrete-Abascal E. SAP expression in Candida albicans strains isolated from Mexican patients with vaginal candidiasis. IJCM. 2013;4(1):25–33. doi: 10.4236/ijcm.2013.41006 [DOI] [Google Scholar]
- 3.Boros E, Pfliegler WP, Kovács R, Jakab Á. Candida albicans isolates from a single hospital show low phenotypical specialization. J Basic Microbiol. 2017;57(11):910–921. doi: 10.1002/jobm.v57.11 [DOI] [PubMed] [Google Scholar]
- 4.Wypij M, Czarnecka J, Dahm H, Rai M. Silver nanoparticles from Pilimelia columellifera subsp. Pallida SL19 strain demonstrated antifungal activity against fungi causing superficial mycoses. J Basic Microbiol. 2017;57(9):793–800. doi: 10.1002/jobm.201700121 [DOI] [PubMed] [Google Scholar]
- 5.Kadry AA, El-Ganiny AM, El-Baz AM. Relationship between Sap prevalence and biofilm formation among resistant clinical isolates of Candida albicans. Afr Health Sci. 2018;18(4):1166–1174. doi: 10.4314/ahs.v18i4.37 [DOI] [PMC free article] [PubMed] [Google Scholar]
- 6.Yao D, Chen J, Chen W, Li Z. Mechanisms of azole resistance in clinical isolates of Candida glabrata from two hospitals in China. Infect Drug Resist. 2019;12:771–781. doi: 10.2147/IDR.S202058 [DOI] [PMC free article] [PubMed] [Google Scholar]
- 7.Gu W, Guo D, Zhang L, Xu D. The synergistic effect of azoles and fluoxetine against resistant Candida albicans strains is attributed to attenuating fungal virulence. Antimicrob Agents Chemother. 2016;60(10):6179–6188. doi: 10.1128/AAC.03046-15 [DOI] [PMC free article] [PubMed] [Google Scholar]
- 8.Copping VM, Barelle CJ, Hube B, Gow NA, Brown AJ, Odds FC. Exposure of Candida albicans to antifungal agents affects expression of SAP2 and SAP9 secreted proteinase genes. J Antimicrob Chemother. 2005;55(5):645–654. doi: 10.1093/jac/dki088 [DOI] [PubMed] [Google Scholar]
- 9.Martinez RC, Franceschini SA, Patta MC, Quintana SM. Improved treatment of vulvovaginal candidiasis with fluconazole plus probiotic Lactobacillus rhamnosus GR-1 and Lactobacillus reuteri RC-14. Lett Appl Microbiol. 2009;48(3):269–274. doi: 10.1111/j.1472-765X.2008.02477.x [DOI] [PubMed] [Google Scholar]
- 10.Sardella D, Gatt R, Valdramidis VP. Assessing the efficacy of zinc oxide nanoparticles against Penicillium expansum by automated turbidimetric analysis. Mycology. 2017;9(1):43–48. doi: 10.1080/21501203.2017.1369187 [DOI] [PMC free article] [PubMed] [Google Scholar]
- 11.Shi XY, Yang YP, Zhang Y, et al. Molecular identification and antifungal susceptibility of 186 Candida isolates from vulvovaginal candidiasis in southern China. J Med Microbiol. 2015;64(4):390–393. doi: 10.1099/jmm.0.000024 [DOI] [PubMed] [Google Scholar]
- 12.Yano J, Sobel JD, Nyirjesy P, et al. Current patient perspectives of vulvovaginal candidiasis: incidence, symptoms, management and post-treatment outcomes. BMC Womens Health. 2019;19(1):48. doi: 10.1186/s12905-019-0748-8 [DOI] [PMC free article] [PubMed] [Google Scholar]
- 13.Mahmoudi Rad M, Zafarghandi S, Abbasabadi B, Tavallaee M. The epidemiology of Candida species associated with vulvovaginal candidiasis in an Iranian patient population. Eur J Obstet Gynecol Reprod Biol. 2011;155(2):199–203. doi: 10.1016/j.ejogrb.2010.11.022 [DOI] [PubMed] [Google Scholar]
- 14.Hosseini SS, Yadegari MH, Rajabibazl M, Ghaemi EA. Inhibitory effects of carvacrol on the expression of secreted aspartyl proteinases 1-3 in fluconazole-resistant Candida albicans isolates. Iran J Microbiol. 2016;8(6):401–409. [PMC free article] [PubMed] [Google Scholar]
- 15.Esteban-Tejeda L, Prado C, Cabal B, Sanz J. Antibacterial and antifungal activity of ZnO containing glasses. PLoS One. 2015;10(7):e0136490. doi: 10.1371/journal.pone.0132709 [DOI] [PMC free article] [PubMed] [Google Scholar]
- 16.Morse DJ, Wilson MJ, Wei X, Bradshaw DJ. Modulation of Candida albicans virulence in in vitro biofilms by oral bacteria. Lett Appl Microbiol. 2019;68(4):337–343. doi: 10.1111/lam.13145 [DOI] [PMC free article] [PubMed] [Google Scholar]
- 17.Kanathila H, Bhat AM, Krishna PD. Antifungal effect of magnesium oxide, zinc oxide, silicon oxide and copper oxide nanoparticles against Candida albicans. The effectiveness of magnesium oxide combined with tissue conditioners in inhibiting the growth of Candida albicans: an in vitro study. Indian J Dent Res. 2011;22(4):613. doi: 10.4103/0970-9290.90324 [DOI] [PubMed] [Google Scholar]
- 18.Ikonomova SP, Moghaddam-Taaheri P, Jabra-Rizk MA, Karlsson AJ. Engineering improved variants of the antifungal peptide histatin 5 with reduced susceptibility to Candida albicans secreted aspartic proteases and enhanced antimicrobial potency. FEBS J. 2018;285:146–159. doi: 10.1111/febs.14327 [DOI] [PMC free article] [PubMed] [Google Scholar]
- 19.Ollert MW, Sohnchen R, Korting HC, Ollert U. Mechanisms of adherence of C. albicans to cultured human epidermal Keratinocytes. Infect Immun. 1993;61(11):4560–4568. doi: 10.1128/IAI.61.11.4560-4568.1993 [DOI] [PMC free article] [PubMed] [Google Scholar]
- 20.Taylor BN, Staib P, Binder A, Biesemeier A. Profile of Candida albicans secreted aspartic proteinase elicited during vaginal infection. Infect Immun. 2005;73(3):1828–1835. doi: 10.1128/IAI.73.3.1828-1835.2005 [DOI] [PMC free article] [PubMed] [Google Scholar]
- 21.Lupetti A, Danesi R, Campa M, Del Tacca M. Molecular basis of resistance to azole antifungals. Trends Mol Med. 2002;8(2):76–81. doi: 10.1016/S1471-4914(02)02280-3 [DOI] [PubMed] [Google Scholar]
- 22.Pam VK, Akpan JU, Oduyebo OO, et al. Fluconazole susceptibility and ERG11 gene expression in vaginal candida species isolated from Lagos Nigeria. Int J Mol Epidemiol Genet. 2012;3(1):84–90. [PMC free article] [PubMed] [Google Scholar]
- 23.Abdullahi Nasir I, Uchenna E, Onyia J, Ifunanya AL. Prevalence of vulvovaginal candidiasis among nonpregnant women attending a tertiary health care facility in Abuja, Nigeria. Res Rep Trop Med. 2015;6:37–42. [Google Scholar]
- 24.Hosseini SS, Roudbarmohammadi S, Joshaghani HR, Eskandari M. Antifungal effect of sodium dodecil sulfate and nanoparticle ZnO on the growth inhibition of standard strain of Candida albicans. J Gorgan Univ Med Sci. 2011;12(4):64–69. [Google Scholar]
- 25.Ozcan SK, Budak F, Yucesoy G, Susever S, Willke A. Prevalence, susceptibility profile and proteinase production of yeasts causing vulvovaginitis in Turkish women. APMIS. 2006;114(2):139–145. doi: 10.1111/apm.2006.114.issue-2 [DOI] [PubMed] [Google Scholar]
- 26.Cho O, Shiokama T, Ando Y, Aoki N. Screening of compounds from an FDA-approved drug library for the ability to inhibit aspartic protease secretion from the pathogenic yeast Candida albicans. Pharm Reg Affairs. 2014;3(5):1000126. [Google Scholar]
- 27.Hosseini SS, Ghaemi E, Noroozi A, Niknejad F. Zinc oxide nanoparticles inhibition of initial adhesion and ALS1 and ALS3 gene expression in Candida albicans strains from urinary tract infections. Mycopathologia. 2019;184(2):261–271. doi: 10.1007/s11046-019-00327-w [DOI] [PubMed] [Google Scholar]
- 28.Panácek A, Kolár M, Vecerová R, Prucek R. Antifungal activity of silver nanoparticles against Candida spp. Biomaterials. 2009;30(31):6333–6340. doi: 10.1016/j.biomaterials.2009.07.065 [DOI] [PubMed] [Google Scholar]
- 29.Kiasat N, Rezaei-Matehkolaei A, Zarei Mahmoudabadi A, Hamidavi Mohamadpour K, Molavi S, Khoshayand N. Prevalence of Vulvovaginal candidiasis in Ahvaz, southwest Iran: a semi-large scale study. Jundishapur J Microbiol. 2019;12(3):1–6. [Google Scholar]
- 30.Hosseini SS, Ghaemi E, Koohsar F. Influence of ZnO nanoparticles on Candida albicans isolates biofilm formed on the urinary catheter. Iran J Microbiol. 2018;10(6):424–432. [PMC free article] [PubMed] [Google Scholar]
- 31.Cannon RD, Lamping E, Holmes AR, et al. Candida albicans drug resistance another way to cope with stress. Microbiology. 2007;153(Pt 10):3211–3217. doi: 10.1099/mic.0.2007/010405-0 [DOI] [PubMed] [Google Scholar]
- 32.Akins RA. An update on antifungal targets and mechanisms of resistance in Candida albicans. Med Mycol. 2005;43(4):285–318. doi: 10.1080/13693780500138971 [DOI] [PubMed] [Google Scholar]